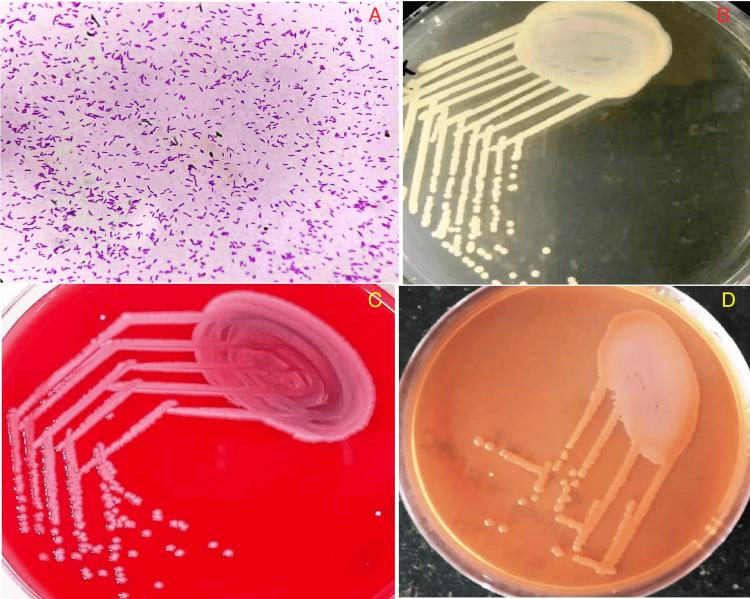
https://cdn.ncbi.nlm.nih.gov/pmc/blobs/9eba/11625513/c7c3ebc687e8/cureus-0016-00000073277-i01.jpg

嗜麦芽窄食单胞菌与血液透析:机会致病菌还是恶意敌人
Stenotrophomonas maltophilia in Hemodialysis: An Opportunistic Pathogen or a Malevolent Foe.
作者信息
V Tamilarasan, V Jagan, Kv Leela, Asokan Arunkumar, George Mathew Gerry, Jayaprakash Varadharajan
机构信息
Microbiology, SRM Medical College Hospital and Research Centre, Chennai, IND.
Nephrology, SRM Medical College Hospital and Research Centre, Chennai, IND.
出版信息
Cureus. 2024 Nov 8;16(11):e73277. doi: 10.7759/cureus.73277. eCollection 2024 Nov.
Catheter-related bloodstream infections (CRBSIs) add to the morbidity and mortality of hemodialysis patients. is an extremely resistant, gram-negative, non-lactose-fermenting nosocomial bacterium that contributes significantly to mortality and morbidity. This bacterium is predominantly associated with community-acquired pneumonia, bacteremia, eye afflictions, biliary sepsis, urinary tract infection, skin and soft tissue infection, and very rarely chronic enteritis with colonic ulcers. Here, we present two cases that presented indolently and exhibit strikingly contrasting behaviors. The first case was a patient with primary hyperoxaluria on maintenance hemodialysis, who presented with CRBSI due to , which responded appropriately to catheter removal and levofloxacin. The second patient, a case of diabetic nephropathy on maintenance hemodialysis, developed CRBSI due to , which initially responded to catheter removal and levofloxacin but was later complicated dramatically by pneumonia and enteritis with colonic ulcers. These cases highlight the variable clinical presentation of this organism and emphasize the need for active surveillance in the dialysis unit.
导管相关血流感染(CRBSIs)增加了血液透析患者的发病率和死亡率。是一种极具耐药性的革兰氏阴性、非乳糖发酵医院细菌,对死亡率和发病率有重大影响。这种细菌主要与社区获得性肺炎、菌血症、眼部疾病、胆源性败血症、尿路感染、皮肤和软组织感染有关,很少与伴有结肠溃疡的慢性肠炎有关。在此,我们报告两例表现隐匿且行为形成鲜明对比的病例。第一例是一名维持性血液透析的原发性高草酸尿症患者,因出现CRBSI,拔除导管并使用左氧氟沙星后病情得到适当缓解。第二例患者是一名维持性血液透析的糖尿病肾病患者,因发生CRBSI,最初拔除导管并使用左氧氟沙星后有反应,但后来因肺炎和伴有结肠溃疡的肠炎而病情急剧恶化。这些病例突出了这种微生物临床表现的多样性,并强调了在透析单元进行主动监测的必要性。